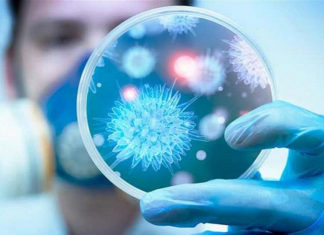

ﻭﻓﺎﺓ ﺃﻭﻝ ﻓﻨﺎﻥ ﻋﺎﻟﻤﻲ ﺟﺮﺍﺀ ﺇﺻﺎﺑﺘﻪ ﺑﻔﻴﺮﻭﺱ ﻛﻮﺭﻭﻧﺎ
المنبر التونسي (كورونا فيروس)- ﺃﻋﻠﻦ ﻓﻲ ﻓﺮﻧﺴﺎ ﺃﻣﺲ ﺍﻟﺜﻼﺛﺎﺀ ﻋﻦ ﻭﻓﺎﺓ ﻋﺎﺯﻑ ﻣﻮﺳﻴﻘﻲ ﻣﺸﻬﻮﺭ ﻣﺘﺄﺛﺮﺍ ﺑﺈﺻﺎﺑﺘﻪ ﺑﻔﻴﺮﻭﺱ ﻛﻮﺭﻭﻧﺎ ﺍﻟﺠﺪﻳﺪ .
ﻭﻗﺎﻝ ﺗﻴﻴﺮﻱ ﺩﻭﺭﻭﺑﻴﺮ، ﻧﺎﺷﺮ ﺃﻋﻤﺎﻝ...
ﺍﻟﻌﻼﻗﺎﺕ ﺍﻟﺰﻭﺟﻴﺔ ﻭ ﺍﻟﺤﻤﻞ ﻓﻲ ﺯﻣﻦ ﻛﻮﺭﻭﻧﺎ : ﻫﺬﺍ ﻣﺎ ﻳﻨﺼﺢ ﺑﻪ ﺍﻻﻃﺒﺎﺀ
المنبر التونسي (كورونا فيروس)- ﺩﻕ ﺍﻧﺘﺸﺎﺭ ﻓﻴﺮﻭﺱ ﻛﻮﺭﻭﻧﺎ ﻧﺎﻗﻮﺱ ﺍﻟﺨﻄﺮ ﻓﻲ ﺟﻤﻴﻊ ﻣﺠﺎﻻﺕ ﺍﻟﺤﻴﺎﺓ،ﻭ ﺷﻠﻬﺎ ﻭﺧﺎﺻﺔ ﺍﻟﻤﺠﺎﻻﺕ ﺍﻹﻧﺴﺎﻧﻴﺔ، ﻭﻣﻦ ﺑﻴﻨﻬﺎ ﺍﻟﻌﻼﻗﺎﺕ ﺍﻟﺠﻨﺴﻴﺔ ﺍﻟﺰﻭﺟﻴﺔ ﻭ...
والي تونس: غلق المنطقة الموبوءة أو الولاية ككل أمرًا مطروحا
المنبر التونسي (والي تونس) - اكد صباح اليوم الإربعاء 25 مارس 2020 ،والي تونس الشاذلي بو علاق بأن عدد المصابين في بفيروس كورونا في ولاية تونس 32 شخصا
وزير الصّحة يُنبّه المواطنين من استعمال دواء “الكلوروكين”
المنبر التونسي(وزير الصحة) - قال وزير الصّحة عبد اللطيف المكي ، مساء الثلاثاء، أنّه تقرّر السماح بإستعمال دواء "الكلوروكين" مع أدوية أخرى.
وأضاف الوزير ،...
دواء عمره مائة سنة قد يكون فعالا في القضاء على فيروس كورونا
المنبر التونسي(كورونا) - باشر عدد الأطباء ومراكز الأبحاث من أربع دول تجاربهم من أجل التأكد من مدى قدرة الدواء الذي اكتشف قبل قرن كامل...
معهد باستور تونس يشرع في إجراء التحاليل لتقصي فيروس كورونا
المنبرالتونسي(معهد باستور) - تشرع مخابر معهد باستور تونس في إجراء تحاليل مخبرية لتشخيص فيروس كورونا المستجد قصد معاضدة جهود المخبر المرجعي بشارل نيكول، وفق...
مرعب : ﺃﻟﻤﺎﻧﻴﺎ .. 4764 ﺣﺎﻟﺔ ﺇﺻﺎﺑﺔ ﺟﺪﻳﺪﺓ ﺑـ ” ﻛﻮﺭﻭﻧﺎ ” ﺧﻼﻝ 24...
المنبر التونسي (كورونا فيروس)- ﻗﺎﻝ ﻣﻌﻬﺪ ﺭﻭﺑﺮﺕ ﻛﻮﺥ ﻟﻸﻣﺮﺍﺽ ﺍﻟﻤﻌﺪﻳﺔ ﺍﻟﻴﻮﻡ ﺍﻟﺜﻼﺛﺎﺀ ﺇﻥ ﺣﺎﻻﺕ ﺍﻹﺻﺎﺑﺔ ﺍﻟﻤﺆﻛﺪﺓ ﺑﻔﻴﺮﻭﺱ ﻛﻮﺭﻭﻧﺎ ﻓﻲ ﺃﻟﻤﺎﻧﻴﺎ ﺧﻼﻝ ﺍﻟـ 24 ﺳﺎﻋﺔ...
ﻛﻴﻒ ﻳﻬﺮﺏ ﺃﺛﺮﻳﺎﺀ ﺍﻟﻌﺎﻟﻢ ﻣﻦ ﻓﻴﺮﻭﺱ ﻛﻮﺭﻭﻧﺎ؟
المنبر التونسي (كورونا فيروس)- ﻳﺤﺎﻭﻝ ﺍﻟﺠﻤﻴﻊ ﺗﻨﻔﻴﺬ ﺗﻌﻠﻴﻤﺎﺕ ﻣﻨﻈﻤﺔ ﺍﻟﺼﺤﺔ ﺍﻟﻌﺎﻟﻤﻴﺔ ﻟﺘﻔﺎﺩﻱ ﺍﻹﺻﺎﺑﺔ ﺑﻔﻴﺮﻭﺱ ﻛﻮﺭﻭﻧﺎ ﺍﻟﻤﺴﺘﺠﺪ، ﻭﺑﻴﻨﻤﺎ ﻳﻠﺘﺰﻡ ﺍﻟﻤﻮﺍﻃﻨﻮﻥ ﺍﻟﻌﺎﺩﻳﻮﻥ ﺑﺘﻌﻠﻴﻤﺎﺕ ﺩﻭﻟﻬﻢ ﺑﺎﻟﺒﻘﺎﺀ ﻓﻲ...
ﺑﻴﻨﻬﻢ ﺃﺭﺩﻧﻲ ﻭﺳﻮﺭﻱ .. ﻓﻴﺮﻭﺱ ﻛﻮﺭﻭﻧﺎ ﻳﻘﻀﻲ ﻋﻠﻰ 24 ﻃﺒﻴﺒﺎ
المنبر التونسي (كورونا فيروس)- ﻓﻘﺪ ﺍﻹﻃﺎﺭ ﺍﻟﻄﺒﻲ ﺍﻻﻳﻄﺎﻟﻲ ﻓﻲ ﻣﻮﺍﺟﻬﺘﻪ ﻟﻔﻴﺮﻭﺱ ﻛﻮﺭﻭﻧﺎ ﻟﺤﺪ ﻫﺬﺍ ﺍﻟﻴﻮﻡ 24 ﻃﺒﻴﺒﺎ ﺍﻳﻄﺎﻟﻴﺎ ﺑﻴﻨﻬﻢ ﺍﺛﻨﺎﻥ ﻋﺮﺑﻴﺎ ﺍﻻﺻﻞ ﺍﺭﺩﻧﻲ ﻭ...
اكتشاف جديد يكشف مدة عيش فيروس كورونا في الهواء وفوق كل جسم (تفاصيل)
المنبر التونسي (مدة عيش فيروس كورونا) - أظهرت تحاليل تم القيام بها مؤخرا مدة عيش فيروس كورونا. المعهد الأمريكي للأبحاث قام بأبحاث حول عيش الفيروس كوفيد-19